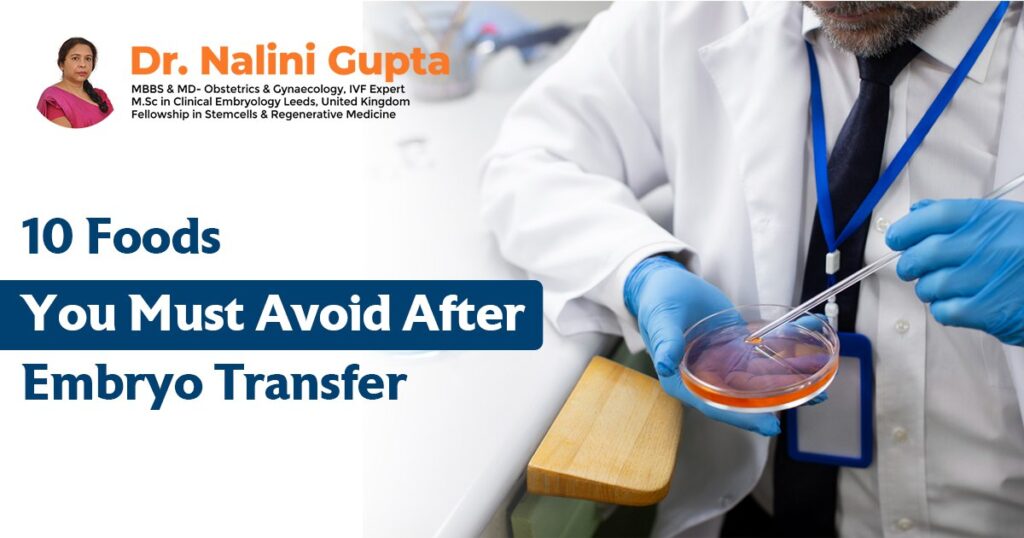

Irregular Periods: Exploring Causes, Impacts, and Solutions for Reproductive Health
As we journey through the intricate landscape of reproductive health, irregular periods emerge as a common but often overlooked concern. Dr. Nalini Gupta from Delfinium Fertility and IVF Centre, renowned as the Best IVF Consultant in Delhi sheds light on the multifaceted dimensions of irregular menstrual cycles. In this exploration, we unravel the causes behind […]
Irregular Periods: Exploring Causes, Impacts, and Solutions for Reproductive Health Read More »